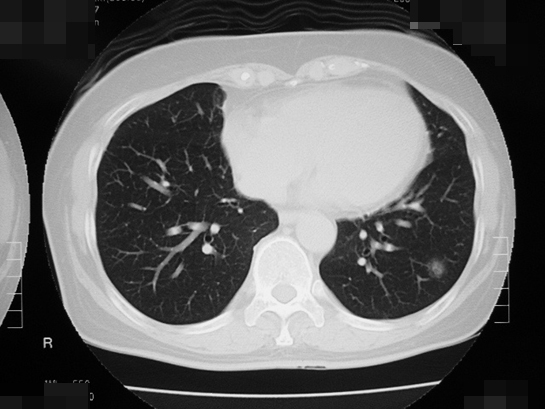

40歳を過ぎたら一度はCTを撮ってみてはいかがでしょうか。
タバコを吸わない女性に増加している肺がんとは?
NPO法人女性呼吸器疾患研究機構 理事長
宮元 秀昭
年間死亡者数が7万5585人(男性5万3247人、女性2万2338人:2020年国立がん研究センターがん統計)と、がんのなかで最も亡くなる方が多いのが肺がんです。発見された時点で、治るための手術を受けられる人は4割程度と少なく、難治性がんの1つです。
ご存知のように肺がんは喫煙と最も関係のあるがんの1つですが、その肺がんの中で最も多い「肺腺がん」は、タバコを吸わない人でもなるがんです。肺がんといえば、長年の喫煙が原因だと考える人も多いと思いますが、喫煙の影響が非常に大きいのは「肺扁平上皮がん」と「肺小細胞がん」です。「肺腺がん」も喫煙がリスクになりますが、喫煙習慣のない若い女性にも起こることが多く、近年増加しています。その原因はよくわかっていません。たばこを吸わないから肺がんにならないというわけではないのです。肺がんが厄介なのは、早期がんでは自覚症状がなく、検診のX線検査で疑われて見つかることもありますが、咳、痰、血痰、呼吸困難、胸痛などの症状が表れると進行がんになっていることが多いという特徴です。
近年増加しているタバコを吸わない女性に多い「肺腺がん」とは、ごく早期のすりガラス陰影といわれるCT検査でしか見えないようながんで、周辺部の影が淡く、直径1.5cm以下であれば、日本肺癌学会のガイドラインでは経過観察でよいとされています。比較的おとなしいがんで、1cm以下のすりガラス状の肺腺がんで女性の場合は、5年後にがんが大きくなっている人は1割程度で、残りの9割の人は大きくならないで、なかには一生そのままの状態の人もいたとの報告もあります。経過観察して、たとえば5年たって大きくなったならその時に、肺を部分的に切除する手術をすればよく、術後の抗がん剤治療も必要ありません。ただ、肺の正常な部分とがん化したすりガラス状に映る影との境界線がはっきりしていたり、影の中にくっきりした部分が広がっている場合は早期ではない可能性があり、注意が必要です。さらに、多発しやすいという性質もあります。
上記で示した「肺腺がん」は、肺がんの中でも最も発症頻度が高く、現在も増加傾向にあります。しかしながら、肺がんの危険因子である喫煙との関連が比較的弱く、喫煙以外の危険因子が特定されていないため、発症リスクの予測や発症予防が難しいという課題があります。そのため、新しい危険因子の同定とそれに基づく罹患危険度の診断法が求められています。また、肺腺がんの発症には人種差があることが知られており、非喫煙者における発症頻度が欧米人と比較してアジア人で高いことが報告されています。そこで国立がん研究センターらは、肺腺がんへの罹りやすさを決める遺伝子の個人差(遺伝子多型)を同定するとともに、欧米人との比較を行いました。具体的には、日本人を含むアジア人の肺腺がん患者約2万例と肺がんに罹患していない人約15万例についてゲノム解析(遺伝子解析)を実施し、その結果、次の3つのことを明らかにしました。
1.アジア人における肺腺がんリスクを決める28個の遺伝子に個人差が見られる。
2.アジア人の遺伝子の個人差は、欧米人患者の肺腺がんリスクを決める遺伝子の個人差と比較して数が多い。
3.非喫煙者における肺腺がんリスクは、喫煙者と比較して遺伝子の個人差の影響が大きい。
以上の遺伝子の個人差の研究結果を用いることにより非喫煙者における肺腺がん危険因子を推定できることが分かりましたので、今後、タバコ以外のさまざまな危険因子を同定するなどによって、肺がん個別化予防対策がなされることが期待されます。(研究の詳細は英科学誌「Nature Communications」に掲載されています。)
われわれNPO法人では、女性肺がんの早期発見のために、胸部CT検査を推奨しています。検診で行われる胸部レントゲン検査では、上に述べたような早期肺がんの発見は困難です。すりガラス陰影を見つけるのは胸部X線では無理です。現にCT検査によって、早期の肺がん、とくにタバコを吸わない若い女性で、肺腺がんが多く発見されています。タバコを吸わない人であっても、年に1回程度胸部CTを撮っていれば手遅れの肺がんが見つかることはありません。40歳を過ぎたら一度はCTを撮ってみてはいかがでしょうか。
バコを吸わない女性に多い肺がんのCT画像